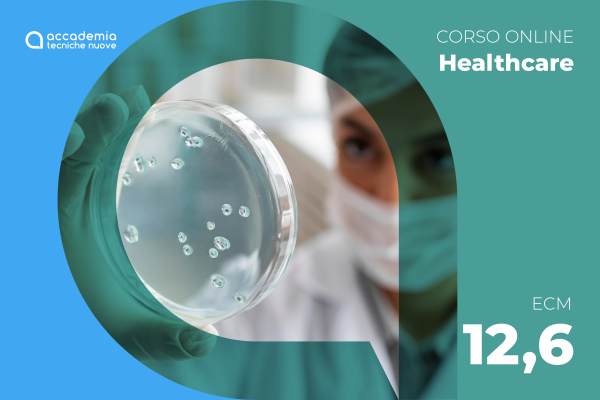

Modulo didattico 1 - ANTIMICROBICO RESISTENZA E CORRETTO USO DEGLI ANTIBIOTICI
Autore: Annalisa Barbieri
Abstract: ogni antibiotico ha un suo spettro di azione, è efficace nei confronti di determinate specie batteriche ad esso sensibili. Si parla di resistenza quando la terapia antibiotica risulta inefficace. Tale fenomeno è legato alle caratteristiche del batterio, infatti può succedere che in determinate circostanze una specie batterica normalmente sensibile a una certa classe di antibiotici diventi resistente. Il pericolo della resistenza agli antibiotici può riguardare tutti i soggetti, ma è maggiore per coloro che hanno un sistema immunitario debole, come ad esempio i malati cronici e i bambini. La causa principale dell’insorgere di resistenze batteriche è l’uso eccessivo e scorretto degli antibiotici. Si possono aggiungere problemi legati alla dose, al modo di somministrazione e alla durata della terapia. È una realtà mondiale sempre più comune, tanto che l’Organizzazione Mondiale della Sanità sottolinea che ogni anno 700 mila persone nel mondo muoiono a causa di un'infezione dovuta a batteri resistenti agli antibiotici, inoltre prevede dieci milioni di morti all’anno nel 2050.
Una migliore cultura sanitaria a tutti i livelli, quindi l’aggiornamento continuo da parte dei medici e la corretta informazione dei pazienti può essere utile nell’affrontare il problema. Risulta necessaria una diagnosi precisa, per decidere se prescrivere gli antibiotici e per la scelta del principio attivo più adatto. D’altro canto, una diagnosi corretta potrebbe non essere possibile nell’immediato in quanto i segni obiettivi di una determinata patologia infettiva potrebbero manifestarsi dopo uno o due giorni dai primi sintomi non peculiari. In questo caso una terapia antibiotica troppo precoce può essere una terapia sbagliata. L’aderenza alla terapia è fondamentale per raggiungere la guarigione.
Modulo didattico 2 - TEST RAPIDI PER AUMENTARE L’APPROPRIATEZZA PRESCRITTIVA DEGLI ANTIBIOTICI
Autore: Francesco Carlo Gamaleri
Abstract: la proteina C reattiva (PCR) o C-Reactive Protein (CRP secondo l’acronimo inglese) è una glicoproteina appartenente al gruppo delle proteine dette “di fase acuta”, prodotta dal fegato e rilasciata in circolo in risposta ad una condizione infiammatoria attiva dell’organismo. La determinazione della PCR permette di misurare la quantità di proteina presente nel sangue, al fine di rilevare uno stato infiammatorio di tipo acuto (infezioni batteriche o fungine, traumi) oppure monitorare la progressione di una malattia infiammatoria cronica.
La misurazione della PCR può essere effettuata in laboratorio analisi in seguito a prelievo venoso oppure in ambito territoriale di prossimità con l’ausilio di apparecchiature certificate CE (point of care test – POCT) presso ambulatori medici, nelle farmacie territoriali che hanno attivati il servizio di analisi di prima istanza, oppure in modalità autotest domiciliare.
I principali punti di forza sono certamente costituiti dalla qualità-rapidità di risposta e la facile accessibilità esecutiva sul territorio da parte di pazienti ed utenti.
Dunque, i test rapidi offrono un'importante opportunità per migliorare l'appropriatezza nella prescrizione di antibiotici consentendo di distinguere rapidamente tra infezioni virali, per le quali gli antibiotici sono inefficaci, e infezioni batteriche, dove possono essere necessari.
L'integrazione dei test rapidi nelle pratiche cliniche può ridurre significativamente l'uso inappropriato di antibiotici, migliorando così i risultati sanitari, riducendo la pressione selettiva sulla resistenza antimicrobica e ottimizzando la gestione delle infezioni.